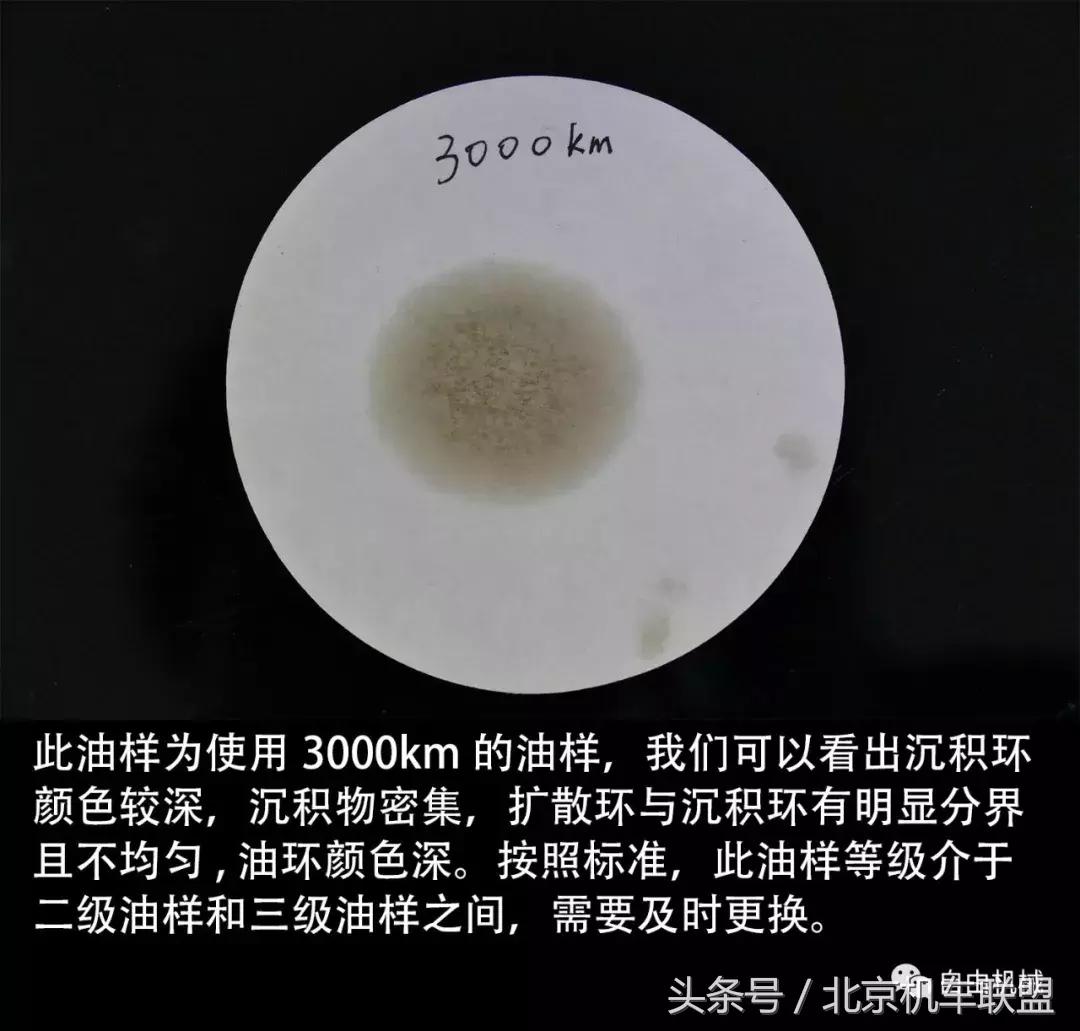
摩托车真机油和假机油有什么区别,怎样鉴别摩托车机油是否正常

作者:瑞天 自由机械
小A说“我的XXX机油很不错,用到3000km仍然很顺滑”,小B却说“什么?不可能,我才2000km换挡就不畅了!”,这时小C插嘴“你们说的都不对,这油1000km就不好用了!”
以上的这种争论在摩托圈里不绝于耳,究竟小A、小B、小C谁说的对呢?

其实机油的更换周期从来没有定数,要根据车型不同、骑行环境不同、骑行习惯选择合适的更换周期。怎样观察机油的损耗程度呢?今天就来详细讨论一番~
在机油使用过程中,究竟是什么导致了机油的劣化?
为了回答“到底应该如何观察机油的劣化程度?”这个问题,我们不妨先思考在机油的使用过程中,究竟是什么导致了机油的劣化?
懒得看直接看答案:
简单的说,机油的劣化过程即金属杂质的增加过程与添加剂的减少过程,当这个过程进行到一定阶段时,机油便不能保证应有的润滑效果,我们便需要对其进行更换。
认真追根究底请看:
Josef Glos在论文Monitoring of element during lifetime of engine oil(机油寿命内元素情况的监控)中探讨了在机油使用过程中其关键化学元素的变化与机油剩余寿命之间的关系。
文中指出,在机油的使用过程中,机油中的金属含量会随着使用过程上升;而添加剂含量会随使用过程下降。
根据金属增加量以及添加剂元素的减少量来衡量机油寿命,当金属含量上升时则说明机油内杂质含量增多,当添加剂元素减少时则说明机油性能劣化。伴随着金属碎屑的增多以及添加剂的消耗,机油也就完成了润滑使命,当机油寿命耗尽时,需要及时对机油进行更换。文中利用光谱化学元素分析衡量机油使用过程中各物质含量的变化。

图为机油中金属含量的增多量,其变化过程表现了机油中杂质的增加情况。横坐标为油样行驶距离,纵坐标为金属含量,单位为mg/kg。
从图中可以看到,机油中金属含量变化幅度最大的是铜和铁。在大多数发动机中,这两种金属多作为发动机的结构性材料。铜含量从1mg/kg增加至5mg/kg,铁含量从2mg/kg增加到了7mg/kg。这些元素含量表现了机油中杂质的变化量。

图为机油添加剂的重要化学元素的减少量,其变化过程反映了机油性能的下降情况。横坐标为里程数,纵坐标为添加剂含量,单位为mg/kg。
从图中可以看到,机油中添加剂化学元素含量随着里程数的增多而下降。锰元素和钼元素的下降量非常轻微,同时硼元素含量却随着里程数下降十分明显。硼元素是抗腐蚀添加剂的主要成分。
使用机油试纸观察机油劣化程度
可能有读者读完上文可能会问“我已经知道机油是为什么变差的了,但是我应该怎么看呢?金属含量与添加剂含量又看不见摸不着,应该怎么办呢?”
我们请出一位鉴定机油质量的小帮手——机油试纸。当机油成分发生变化时,机油在试纸上的扩散程度、杂质集中程度和颜色也会有所变化,通过观察这一变化,即可大概知晓机油的剩余寿命。

机油试纸
在使用机油滤纸时,仅需要滴一到两滴油样到机油试纸上,然后耐心等待4个小时左右,观察油斑在机油试纸上的扩散情况即可轻松鉴别当前油样的剩余寿命。

机油试纸扩散图
如何根据机油试纸的情况来分析当前机油情况呢?按照扩散情况,可把机油分成四个等级。


油样分级
当机油试纸出现三级、四级的扩散情况时,机油质量已经急剧下降,不能再保证基本的润滑效果了,需要进行及时更换。
自由机械在编辑部内展开了测试~全新的机油对比700km没换机油的本田dio、1000km没换机油的春风150nk、以及编辑部贱贱同学已经3000km没换机油的雅马哈R15。三位车主骑行方式都比较*力暴**,基本上损耗速度在同一水平线上。

取3000km的雅马哈R15油样

取700km的本田dio油样
首先要说明的是,不同的人和不同的车对机油劣化程度的敏感度不同,所以不能单单以感觉来评定机油寿命,因此机油试纸仅能对当前油样的劣化程度负责。

四组油样
首先我们来看新机油在机油试纸上的扩散情况。从扩散情况上看,机油清澈且无任何油环分界情况,不属于以上四种分级情况中的任何一种,这里利用新机油的扩散情况作为参考。

全新油样
下面我们来观察仅700km的dio油样,作为踏板车机油,由于其风冷散热方式以及cvt传动方式的原因,其使用环境相对于档车更为恶劣。

700km
下面对比1000km的春风150nk油样,看看在差不多里程数的情况下机油在档车和踏板车上的表现有何不同。

1000km
1000km的春风150nk油样品质良好,完全可以继续使用,看来机油在1000公里左右的保护性还处于巅峰状态。
这时候贱贱同学不服气了,表示对机油试纸的结果不满意,说“我才不信机油试纸,无论多少公里样子都是一样的!”为了打消贱贱同学的疑虑,我们把贱贱同学3000km的R15机油滴到了机油试纸上。
结果却...
3000km
“啊我的机油怎么会这样!这哪能继续用呀!”
贱贱同学恍然大悟,终于明白了机油试纸的作用。看到自己爱车的“血液”状况如此糟糕,他立马扔下了手中的稿子,出发去做保养了。
“回来,回来~稿子还没写完!”
“不管了!我得赶快给我的车换血!”
在大家平时的骑车、玩车过程中,充分了解自己车辆的车况并按时进行保养与维护。按时保养、维护车辆不仅仅是保证车辆寿命的前提,更是车辆安全的一道重要防线。
切记用科学的方式保养与维护车辆,这样它才能陪伴大家走的更远。
喜欢摩托车就关注一下呗
留言给小编一起聊摩托吧!